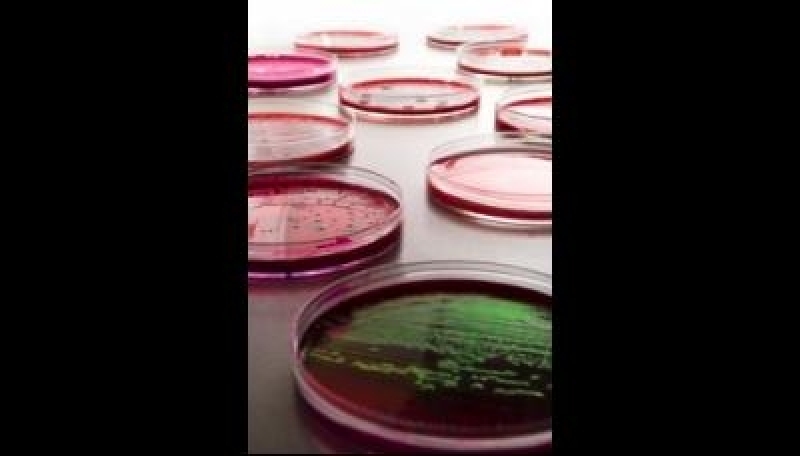
0472319658

Te mooi om waar te zijn
Zijn naam was Fleming, hij was een arme Schotse landbouwer. Op een dag, terwijl hij probeerde om het leven voor zijn familie aangenaam te maken, hoorde hij een schreeuw om hulp uit een nabijgelegen moeras. Hij liet alles vallen en rende er heen. Met zijn taille tot in de zwarte smurrie zag hij een bange jongen gillen en worstelen. De landbouwer Fleming redde de jongen van wat een langzame en angstaanjagende dood geweest had kunnen zijn.
De volgende dag kwam een koets aan bij het huis van de boer. Een elegant geklede man stapte uit en introduceerde zich als de vader van de jongen die boer Fleming had gered. "Ik wil u terugbetalen," zei hij. "U redde het leven van mijn zoon." "Meneer, ik kan niets aanvaarden voor wat ik deed", antwoordde de Schotse landbouwer ondanks de aanbieding.
Op dat ogenblik, verscheen de eigen zoon van de landbouwer aan de deur van de boerderij. "Is dat uw zoon?" vroeg de edelman. " Ja," antwoordde de landbouwer trots. "Ik wil met u een overeenkomst maken. Laat me hem van het niveau van onderwijs voorzien zoals dat waarvan mijn eigen zoon zal genieten. Hij zal zonder twijfel een mens worden waar wij beiden trots op zullen zijn." En zo gebeurde. De zoon van Fleming studeerde op de beste scholen en hij behaalde op St. Mary Medical School van het ziekenhuis in Londen een diploma. Hij werd over de hele wereld bekend als Alexander Fleming, uitvinder van de penicilline.
Jaren later werd de zoon van de edelman, die uit het moeras was gered, getroffen door een longontsteking. Wat redde zijn leven dit keer? Penicilline.
De naam van edelman? Lord Randolph Churchill. De naam van zijn zoon? De heer Winston Churchill.
Laura Koppenberg
24 januari 2012
Noot. Het is een bekende anekdote waar onze harten natuurlijk direct warm van worden. Wat een mooi verhaal en wat een wonderlijke speling van het lot, als het écht zo was gegaan. Helaas blijkt bij nader onderzoek dat het een broodje aap-verhaal is. Maar dat maakt de hartverwarming en het ohhh- en ahhh-gevoel er niet minder op. Toch?
Overigens. De uitvinding van de penicilline was voor Fleming ook een gevalletje omdenken. Het was namelijk....volslagen toeval. Fleming ruimde zijn laboratorium op, toen het hem opviel dat een schimmel zich had gehecht op een kweekplaat met kolonies stafylokokkenbacteriën. Rondom de schimmel lag een zone waarin geen bacteriën groeiden. Fleming analyseerde de door de schimmel uitgescheiden stof en dat bleek penicilline te zijn. (Bron: Ja-maar®...Huh?! - de techniek van het omdenken)